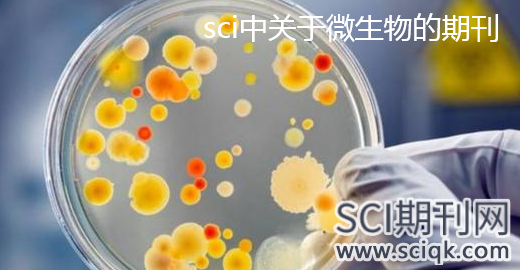

SCI论文发表 2022-03-10
微生物包括:细菌、真菌以及一些小型的原生生物、显微藻类等在内的一大类生物群体以及病毒,它个体微小、种类繁多、与人类关系密切。sci中关于微生物的期刊有哪些?平台学术顾问为大家做出了详细介绍,供大家参考,希望能够给大家带来帮助。
ACTA PROTOZOOLOGICA
ANAEROBE
Annual Review of Microbiology
ANTIMICROBIAL AGENTS AND CHEMOTHERAPY
ANTONIE VAN LEEUWENHOEK INTERNATIONAL JOURNAL OF GENERAL AND MOLECULAR MICROBIOLOGY
ARCHIVES OF MICROBIOLOGY
BMC MICROBIOLOGY
BRAZILIAN JOURNAL OF MICROBIOLOGY
Cell Host & Microbe
CLINICAL MICROBIOLOGY REVIEWS
CRITICAL REVIEWS IN MICROBIOLOGY
CURRENT MICROBIOLOGY
ENVIRONMENTAL MICROBIOLOGY
EUROPEAN JOURNAL OF PROTISTOLOGY
FEMS MICROBIOLOGY ECOLOGY
FEMS MICROBIOLOGY LETTERS
FEMS MICROBIOLOGY REVIEWS
Future Microbiology
INTERNATIONAL JOURNAL OF MEDICAL MICROBIOLOGY
INTERNATIONAL JOURNAL OF SYSTEMATIC AND EVOLUTIONARY MICROBIOLOGY
JOURNAL OF BACTERIOLOGY
JOURNAL OF BASIC MICROBIOLOGY
JOURNAL OF CLINICAL MICROBIOLOGY
JOURNAL OF EUKARYOTIC MICROBIOLOGY
JOURNAL OF MEDICAL MICROBIOLOGY
JOURNAL OF MICROBIOLOGY
MICROBIOLOGICAL RESEARCH
MICROBIOLOGY
MICROBIOLOGY AND MOLECULAR BIOLOGY REVIEWS
MICROBIOLOGY-SGM
MIKROBIYOLOJI BULTENI
NATURE REVIEWS MICROBIOLOGY
New Microbiologica
Polish Journal of Microbiology
Postepy Mikrobiologii
PROTIST
RESEARCH IN MICROBIOLOGY
REVISTA ARGENTINA DE MICROBIOLOGIA
Revista Espanola de Quimioterapia
SYMBIOSIS
VETERINARY MICROBIOLOGY
mBio
Annals of Clinical Microbiology and Antimicrobials
ARCHAEA-AN INTERNATIONAL MICROBIOLOGICAL JOURNAL
Beneficial Microbes
Jundishapur Journal of Microbiology
Frontiers in Microbiology
MicrobiologyOpen
Journal of Oral Microbiology
Microbiome
以上介绍了sci中关于微生物的期刊,除了以上sci期刊外,还有更多相关sci期刊,如果您想要了解更多,可咨询我们在线专业人员。
文章名称:sci中关于微生物的期刊
112751拥有老客户
108539评职称指导
63352国际学术服务
219867开具合同